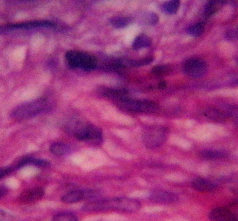

不孕不育成为现在较为普遍的现象,患有不孕不育的几率越来越高,那么,为什么治疗不孕不育要趁早呢?下面,我们就一起来了解下。
1、女性年龄是影响生育能力的较重要因素
女性较佳的生育年龄是25-29岁,30岁以后女性生殖能力开始下降,35岁以后生殖能力直线下降,而40岁后女性逐渐进入围绝经期,鲜有成功妊娠者。在不孕症的诊治中,就诊年龄与不孕症治疗效果有直接关系。即使在试管婴儿治疗中,当女方年龄小于35岁,成功怀孕的几率更大。因此如发现不孕,较好在35岁以前就诊。但年轻女性应重视卵巢的年龄。有些女性虽然年纪很轻,但卵巢功能已经开始衰减,20多岁时卵巢的年纪已经相当于40岁近绝经的情况,这种不孕症患者治疗起来就比较困难。所以不孕症的治疗应抓紧时间,不宜拖拖拉拉。
2、出生畸形儿与年龄有关
女性超过35岁后,胎儿畸形的发生率呈增加局势。研究表明,25-29岁女性中,生育先天愚型婴儿的发生率仅为1/1500,30-34岁为1/900,35-39岁为1/300,45岁以上者达到1/40。
对于男性而言,年龄与精子质量以及婴儿的健康也密切相关。25-35岁男性精子质量较好,40岁以后,精子质量逐渐下降。随着年龄增加,男性的精子染色体异常也增加,如果父亲年龄超过40岁,子女发生畸形者增加一倍。
以上就是关于治疗不孕不育要趁早的相关内容,希望对大家有所帮助,如还有不清楚的点击在线咨询,专家第一时间为您解答。
温馨提示:北京家圆医院是北京市卫健委审批通过的合法开展辅助生殖技术(试管婴儿)的正规医院,做辅助生殖技术(试管婴儿)请到北京市卫健委批准的,有资质、正规辅助生殖医院。
 人到高龄深感备孕“力不从心”?这些建议或
人到高龄深感备孕“力不从心”?这些建议或 “黄体破裂群”再添新成员!这次”凶手“竟
“黄体破裂群”再添新成员!这次”凶手“竟 不满父母催婚,26岁女生竟赌气“上环”:
不满父母催婚,26岁女生竟赌气“上环”: 无锡二孩及以上家庭可再购一套房!“鼓励生
无锡二孩及以上家庭可再购一套房!“鼓励生 糖尿病会影响生育健康么?专家给出了这样的
糖尿病会影响生育健康么?专家给出了这样的 输卵管积水是该切除还是治疗?生殖专家给出
输卵管积水是该切除还是治疗?生殖专家给出 什么是囊胚移植?它的受孕率真的是最高的么
什么是囊胚移植?它的受孕率真的是最高的么 21年生了15个娃!这对广西夫妻的生育经
21年生了15个娃!这对广西夫妻的生育经 全麻抽脂后意外发现怀孕6周!孕妇真的不能
全麻抽脂后意外发现怀孕6周!孕妇真的不能 多囊卵巢做试管,做好下面3点,可提高试管
多囊卵巢做试管,做好下面3点,可提高试管 取卵切勿贪多,卵子数并不能决定试管成功率
取卵切勿贪多,卵子数并不能决定试管成功率 查出巧克力囊肿该咋办?专家教你如何应对最
查出巧克力囊肿该咋办?专家教你如何应对最 小伙相亲惨遭“十连败”!拒绝原因竟是 .
小伙相亲惨遭“十连败”!拒绝原因竟是 . 白头发拔一根长十根?长的越多肾越不好?真
白头发拔一根长十根?长的越多肾越不好?真 好大儿?5岁熊孩子一脚把老妈踢进医院,结
好大儿?5岁熊孩子一脚把老妈踢进医院,结 美国女孩假扮孕妇求助中国路人帮系鞋带,测
美国女孩假扮孕妇求助中国路人帮系鞋带,测 谈谈备孕路上的7只“拦路虎”!学会了你就
谈谈备孕路上的7只“拦路虎”!学会了你就 输卵管的自白!它做了一个违背祖宗的决定!
输卵管的自白!它做了一个违背祖宗的决定!网站声明:
本站内容涉及转载均出于互联网,对有明确来源的都注明了出处,版权归原作者及网站所有,北京家圆医院不承担任何法律责任。如果您对于我们的使用有任何的疑问,请及时与我们联系,以便我们迅速做出处理。